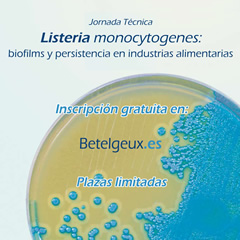
jornada-listeria

Esta Jornada Ténica, organizada por el CNTA y Betelgeux, se centrará en las soluciones a la problemática que supone la bacteria Listeria monocytogenes en las industrias alimentarias: estrategias de control, detección y eliminación de biofilms de manera rápida y visual, prácticas innovadoras en limpieza y desinfección, así como proyectos europeos en busca de la eficiencia en este ámbito.
Esta Jornada Ténica, organizada por el CNTA y Betelgeux, se centrará en las soluciones a la problemática que supone la bacteria Listeria monocytogenes en las industrias alimentarias: estrategias de control, detección y eliminación de biofilms de manera rápida y visual, prácticas innovadoras en limpieza y desinfección, así como proyectos europeos en busca de la eficiencia en este ámbito.
Una bacteria problemática: Listeria monocytogenes
Betelgeux y el Centro Nacional de Tecnología y Seguridad Alimentaria (CENTA) organizan esta Jornada Técnica sobre Listeria monocytogenes, una de las principales causas de muerte por toxiinfección alimentaria, para ofrecer un mayor conocimiento sobre la bacteria y soluciones que minimicen los riesgos de contaminación.
El objetivo de la jornada es abordar esta problemática desde un punto de vista multidisciplinar. Para ello, la jornada contará con representación empresarial, universitaria y de Centro Tecnológico; que permita mezclar innovación y practicidad en las metodologías utilizadas para conseguir un eficaz control de Listeria monocytogenes.
En la jornada participará el Dr. David Rodríguez de la Universidad de Burgos, que hablará sobre aspectos relevantes e implicación en la seguridad alimentaria.
En la jornada participará el Dr. David Rodríguez de la Universidad de Burgos, que hablará sobre aspectos relevantes e implicación en la seguridad alimentaria.
Por parte de CNTA, la Dra. Raquel Virto, Responsable de Bioprocesos del Área de I+D+i, centrará su ponencia sobre la aplicación de la microbiología predictiva para la cuantificación del riesgo de Listeria monocytogenes.
Betelgeux, por su parte, mostrará soluciones para la detección y eliminación de biofilms, protocolos de limpieza y desinfección en industrias alimentarias, así como estrategias de control de Listeria monocýtogenes persistente. Esta última ponencia correrá a cargo del Consejero Delegado de la compañía, Enrique Orihuel, el cual considera "absolutamente necesario" ofrecer conocimientos a la industria en este ámbito, con el fin de "alcanzar los más altos niveles de higiene y garantizar la seguridad de los alimentos".
Programa de ponencias
- Listeria Monocytogenes: aspectos relevantes e implicación en la seguridad alimentaria
Dr. David Rodríguez. Área de Tecnología de los Alimentos de la Universidad de Burgos.
- Detección y eliminación de biofilms
D. Pedro Pozuelo. DSC de Betelgeux
- Aplicación de la microbiologia predictiva para la cuantificación del riesgo de Listeria Monocytogenes
Dra. Raquel Virto. Responsable de Bioprocesos del Área de I+D+i en CNTA
- Limpieza y desinfección en el control de Listeria en industrias alimentarias
D. Juan José Canet. Subdirector del DSC de Betelgeux
- Estrategias de control de Listeria Monocytogenes persistente
Dr. Enrique Orihuel Consejero Delegado de Betelgeux
Información general
Lugar: Sede del CNTA. San Adrián (Navarra)
Fecha: 30 de mayo de 2013
Inscripciones:
Inscripción gratuita. Plazas limitadas
Las inscripciones se podrán realizar directamente a través de la web de Betelgeux: www.betelgeux.es/jornada-listeria , a través del correo electrónico
o llamando al número de teléfono: +34 962 871 345.




